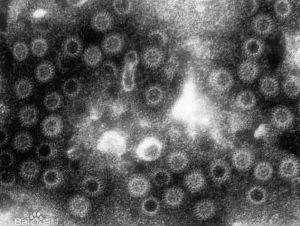
感染性腹瀉

廣義
各種病原體腸道感染引起之腹瀉,均稱為感染性腹瀉,這是廣義上的感染性腹瀉;
什麼是感染性腹瀉
感染性腹瀉
感染性腹瀉(1)細菌性腹瀉是指各種細菌引起的腹瀉。能引起腹瀉的細菌有致瀉性大腸桿菌、沙門氏菌、霍亂弧菌、志賀氏菌、彎曲桿菌等。
(2)由病毒感染引起的腹瀉叫病毒性腹瀉。能引起腹瀉的病毒主要有輪狀病毒、杯狀病毒、腺病毒等。
(3)真菌性腹瀉是指由真菌感染腸道引起的腹瀉。能引起腹瀉的主要病原菌為白色念珠菌、放線菌、新型隱球菌和毛黴菌。
(4)會引起腹瀉的寄生蟲有腸賈第鞭毛蟲、小隱孢子蟲、溶組織阿米巴和環孢子蟲等,他們是兒童急性腹瀉常見的病因。
感染的病原體
 病原體
病原體細菌
目前已知引起腹瀉的細菌有數十種之多1、志賀菌
2、腸致瀉性大腸桿菌:
腸致病性大腸桿菌:引起嬰幼兒水樣或蛋花湯樣便
腸產毒性大腸桿菌:引起病人霍亂樣水樣便
腸侵襲性大腸桿菌:病人發生細菌性痢疾樣便
腸出血性大腸桿菌:病人早期為水樣便,後為血便
大腸桿菌(顯微鏡觀察)
腸集聚性粘附大腸桿菌:與小兒頑固性腹瀉有關
3、空腸彎曲菌
由空腸、結腸彎曲菌引起的腸炎分布較廣,可引起人以及一些家畜或家禽的腹瀉,主要症狀有發熱、腹瀉和腹痛,少數有嘔吐,與細菌性痢疾相似,但病情較輕;
小腸結腸炎耶爾森菌病是主要引起急性腸炎或急性胃腸炎;
4、沙門菌
某些菌型可致人的急性腹瀉和食物中毒暴發
全球已發現2000多個菌型
我國至少已檢出255個型或變異型
其中已知能引起人類致病的有57個型,主要在A——F群內,所以在沙門氏菌血清學鑑定時,可先用A——F多價O血清檢查
鼠傷寒沙門菌感染遍及全國各地,該菌在醫院兒科、產科嬰兒室的交叉感染屢有報告
5、弧菌
在弧菌屬中,把與O1群霍亂弧菌具有共同鞭毛抗原,生化性狀類似,僅菌體抗原不同的弧菌統稱為霍亂弧菌
根據菌體抗原不同,目前已編排到200個以上血清群,除O1/O139群為霍亂的病原體外,其餘統稱為非O1/非O139霍亂弧菌,有些能引起散發性腹瀉或食物型暴發
除霍亂弧菌外,發現有多種致病性弧菌,其中擬態弧菌、河弧菌、弗尼斯弧菌、副溶血弧菌、霍利斯弧菌和少女魚弧菌等可引起腸道感染
病毒
在感染性腹瀉中占有重要的比例病原體包括輪狀病毒、腺病毒、星狀病毒、杯狀病毒等
目前在國內病毒性腹瀉中檢出的主要病原體是輪狀病毒
其他病原體
賈第蟲病是由藍氏賈第鞭毛蟲所致,以兒童多見,多在夏秋季發病。該蟲寄生於腸道,可引起腹瀉、腹痛、吸收不良和粘液性大便;隱孢子蟲能引起隱孢子蟲病,該病是人獸共患疾病,呈世界性分布;
臨床表現
 感染性腹瀉
感染性腹瀉感染性腹瀉
亦可為粘液便、膿血便
可伴有噁心、嘔吐、食欲不振、發熱及全身不適等
病情嚴重者,大量丟失水分引起脫水、電解質紊亂甚至休克
1、分泌性腹瀉
指病原體或其產物作用於腸上皮細胞,引起腸液分泌增多和/或吸收障礙而導致的腹瀉
病人多不伴有發熱,糞便性狀為稀便或水樣便,糞便的顯微鏡檢查多無細胞,或可見少許紅、白細胞
屬於此類腹瀉的除霍亂外,還有腸產毒性大腸桿菌腸炎、致瀉性弧菌腸炎、非O1/非O139霍亂弧菌腸炎、輪狀病毒腸炎、隱孢子蟲腸炎,以及常以食物中毒形式出現的臘樣芽胞桿菌腹瀉,金黃色葡萄球菌腹瀉等
2、炎症性腹瀉
病原體侵襲上皮細胞,引起炎症而致的腹瀉
常伴有發熱,糞便多為粘液便或粘液血便,糞便的顯微鏡檢查見有較多的紅、白細胞
屬於此類感染性腹瀉的除細菌性痢疾外,還有侵襲性大腸桿菌腸炎、腸出血性大腸桿菌腸炎、彎曲菌腸炎、小腸結腸炎耶爾森氏菌腸炎等
病因
感染性腹瀉的原因有很多,也有感染性和非感染性的腹瀉,如果是感染性慢性感染,有細菌感染,有比較特殊的像結核桿菌的感染,也可能造成慢性腹瀉,當然其他的慢性感染也可以。還有一些是非感染一類的,對於慢性腹瀉來講,跟急性腹瀉比較起來非感染的更多見,非感染一大類叫慢性炎症性腸病,包括潰瘍性結腸炎和克羅恩病,另外還有經常服某種藥物引起的慢性腹瀉,另外還有老年人的缺血性腹瀉,一般是急性的,也有慢性缺血性質的,少見一些。
還有腫瘤,有些腫瘤也可以引起。再有一個是吸收不良,還有一類是腸易激綜合症,有些達不到這個標準,但是也屬於功能性的。還有全身疾病也可以引起慢性腹瀉,尿毒症等等,慢性腹瀉很複雜,病因很多,一旦有慢性腹瀉的症狀最好不要掉以輕心,到醫院來看看,首先查明原因是什麼。
感染性腹瀉不明原因只是暫時查不出原因,但是一定是有原因的,這需要通過系統的診斷。常規檢查查不出來的,有些特殊檢查能查出來。在診斷的時候,我們一步一步地從最常規的檢查查起,不會一下子全面地所有檢查一塊兒上,根據病人的臨床表現,他最可能的是什麼,先做那個檢查,除外以後再考慮其他的。明確是什麼原因引起的疾病,才能根據病因做針對性的治療。
分類
感染性腹瀉的種類是比較多的。第一種屬於侵襲性病源引起的腹瀉,這一種像細菌性痢疾,阿米巴痢疾;
第二類就是腸毒素性的腹瀉,也就是說主要致病是通過腸的毒素,這一類病人當中,最重要的是霍亂;
第三類是病毒性感染,病毒性在兒童比較多見。
夏秋季節引起腹瀉的病毒主要是腸道病毒,腸病毒、柯薩克病毒,脊灰病毒,還有到秋天時的輪狀病毒比較多見,在兒童時期,特別是輪狀病毒,全國都比較多發;第四種主要是抗生素相關性的腹瀉,也就是說夏季發生腹瀉,或者是其它疾病以後,用的抗生素過多了,過多、過濫引起均衡失調,均衡失調以後,影響腸道的吸收功能,造成腹瀉感染性腹瀉。是夏秋季節主要的傳染病。
實驗室檢查
糞便常規檢查:糞便可為稀便、水樣便、粘液便、血便、或膿血便。鏡檢可有多量紅、白細胞,也可僅有少量或無細胞病原學檢查:糞便中可檢出霍亂、痢疾、傷寒、副傷寒、腸致瀉性大腸桿菌、沙門菌、輪狀病毒或藍氏賈第鞭毛蟲等,或檢出特異性抗原、核酸或從血清檢出特異性抗體
病原學檢查
標本的收集:標本以病人糞便為主,水樣便採取1——3mL,成感染性腹瀉
形便採取指甲大小的糞量,亦可用直腸棉拭或采便管由肛門插入直腸內3——5cm處採取標本的送檢:採得的標本應立即接種於培養基。不能立即檢查的,要放入鹼性蛋白腖水或文臘二氏保存液或插入Cary-Blair二氏半固體保存培養基中標本與保存液比例約為1∶5
治療原則
一般及對症治療:繼續飲食,積極補液,對症支持,尤其注意改善中毒症狀及糾正水電解質的平衡失調病原治療:針對引起腹瀉的病原體,必要時給予相應的病原治療
預防措施
 預防
預防2改變有些農村人畜共舍的生活習慣。
3免疫接種:本組傳染病病原體種類多,尚沒有理想的免疫製品。
4加強飲用水衛生:要加快城鄉自來水建設及自來水衛生監督管理,在一時達不到要求的地區,必需保護水源,改善飲用水衛生,實行飲用水消毒。
5抓好飲食衛生:加強宣傳和嚴格執行《中華人民共和國食品衛生法》特別要加強對飲食行業、農貿集市、集體食堂等的食品衛生管理。
小兒非感染性腹瀉
小兒非感染性腹瀉主要是由於餵養不當,飲食失調所致。如母乳不足或人工餵養兒,過早過多地以粥類與粉糊餵養小兒,碳水化合物過多能引起發酵產生消化紊亂。未按時添加輔助食品於斷奶前突然增加食物改變食物成分,因不能適應而產生消化紊亂發生腹瀉。也有由於不定時餵養,或由於食量過多過冷影響胃腸道消化功能,均可以引起腹瀉。如進食過多、過少、過熱、過涼,突然改變食物品種等引起,也可由於食物過敏、氣候變化、腸道內雙糖酶缺乏引起。小兒感染性腹瀉主要是由病毒(以輪狀病毒為最多)、細菌、真菌、寄生蟲感染腸道後引起。
春天易得感染性腹瀉
 流食
流食1、因為吃錯東西出現的拉肚子,可以吃黃連素、氟哌酸、瀉立停等藥物。
2、因為著涼出現的拉肚子,很可能是因為腸道中的菌群失調引起的,菌群失調主要是由於過多服用抗生素等原因造成的。可以到醫院的腹瀉門診檢查一下,服用增加有益菌(雙歧桿菌)的藥物,平時多喝些優酪乳製品也有幫助的。
3、如果經常出現腸激惹,可以考慮服用“固本意腸”。
拉肚子吃什麼食物較好?
腹瀉初期,最好吃一些流食,比如濃米湯、稀藕粉、杏仁霜、去油肉湯、淡茶、過濾後的果汁等;情況好轉後再吃一些半流食,如掛麵、面片、白米粥、蒸蛋羹等。但是,不要喝牛奶。因為牛奶雖不含食物纖維,但能在腸道中增加殘渣,讓病情加重。另外,還要注意少食多餐;食物溫度也不宜過冷,否則會引起腸蠕動。
如果是慢性腹瀉,持續的時間較長,會造成身體中一定的營養損失。因此,最好選擇既能補充營養,對腸道刺激又小的食物。常見的有穀類:粥、稀飯、發麵蒸食、麵包、軟麵條、面片等;蛋類:除煎蛋外,其他做法均可;肉類:嫩瘦肉、雞、魚、蝦,最好做得軟、爛一些;豆類:豆漿、豆腐;蔬菜類:含纖維低的蔬菜,如去皮胡蘿蔔、土豆、南瓜、冬瓜、茄子、絲瓜等,但記住,一定要做熟了再吃;甜點心:餅乾、藕粉、蛋糕等。
腹瀉的時候,有些食物最好別吃。比如各種粗糧、老玉米、堅果;生的蔬菜水果。有人認為,越是拉肚子越要吃一些容易消化的蔬菜,這種想法是錯誤的,一些多纖維的蔬菜,如芹菜、韭菜、豆芽、筍類等,吃了反而會加重病情。蔥頭、生蘿蔔等容易脹氣,也要少吃。水果中則不要吃鳳梨、草莓。
此外,拉肚子時最好別吃油炸食品,在烹調上,應多採用蒸、煮、燜等方法。
感染性腹瀉與後遺症
近年來,醫學研究發現,感染性腹瀉的重症表現不僅種類繁多,而且還可導致一些較嚴重的後遺症。
經常發生的有以下幾種:
1、尿毒綜合徵:由出血性大腸桿菌O157引起的最多,還有O26、O111等菌型也可發生,患者以兒童和老年人多見。此征多見於血水樣便或黏液血便患者,並發生在病程的中後期,或突然出現少尿或無尿時。病人嘔吐物可有血性液體,或出現黑便,尿中有蛋白或發生血尿,皮膚可見出血性瘀斑,尤其在曾做注射和體位受壓部位。B超檢查可見腎臟腫大,回聲增強。因此,在抗菌治療中應避免使用腎毒性抗生素。
2、格林—巴利綜合徵:這是一種急性四肢軟癱、肌肉麻痹類疾病,國內外研究認為此病的發生大多與空腸彎曲菌感染有關,是由於激發周圍神經脫髓鞘而引起。空腸彎曲菌在腹瀉病中的感染率僅次於痢疾桿菌,家禽、家畜普遍帶菌。此病多由染菌的豬肉、牛肉、雞肉和牛奶等禽畜食品傳播,被污染的水和蔬菜也可使人感染。大部分患者在腹瀉症狀好轉後出現四肢軟癱,並逐漸加重,以致不能行走。嚴重者可出現飲水嗆咳、咽喉麻痹及呼吸肌麻痹等。此病病死率約為5%,約15%的病例致殘。
3、腸道外的其他重症:表現由於感染性腹瀉病原體種類多、分型複雜,在發生腹瀉時還可引起多種腸道外重症表現,比如,咽峽炎、心肌炎、敗血症、腦炎、腦膜腦炎、肝炎、關節炎、血小板減少性紫癜、肺炎、胸腔積液等。對此,醫生和病人均應注意觀察,及時防治。
預防感染性腹瀉
各種病原體腸道感染引起之腹瀉,均稱為感染性腹瀉,這是廣義上的感染性腹瀉。從狹義上講,我們也把除霍亂、細菌性和阿米巴性痢疾、傷寒和副傷寒以外的感染性腹瀉,稱為感染性腹瀉,為狹義上的感染性腹瀉,為《中華人民共和國傳染病防治法》中規定的丙類傳染病。
那么,怎樣做好預防感染性腹瀉的工作呢?主要要從以下幾個方面著手:
1、健康教育:加強以預防腸道傳染病為重點的衛生宣傳教育,搞好環境衛生,提倡喝開水,不吃生的半生的食品。
2、改變有些農村人畜共舍的生活習慣。
3、免疫接種:本組傳染病病原體種類多,尚沒有理想的免疫製品。
4、加強飲用水衛生:要加快城鄉自來水建設及自來水衛生監督管理,在一時達不到要求的地區,必需保護水源,改善飲用水衛生,實行飲用水消毒。
5、抓好飲食衛生:加強宣傳和嚴格執行《中華人民共和國食品衛生法》特別要加強對飲食行業、農貿集市、集體食堂等的食品衛生管理。
中國國家法定傳染病
| 甲類傳染病(2種): | 鼠疫| 霍亂 |
| 乙類傳染病(26種): | 病毒性肝炎 | 細菌性和阿米巴性痢疾 | 傷寒和副傷寒 | 愛滋病 | 淋病 | 梅毒 | 脊髓灰質炎 | 麻疹 | 百日咳 | 白喉 | 流行性腦脊髓膜炎 | 猩紅熱 | 流行性出血熱 | 狂犬病 | 鉤端螺鏇體病 | 布魯氏菌病 | 炭疽 | 流行性和地方性斑疹傷寒 | 流行性乙型腦炎 | 黑熱病 | 瘧疾 | 登革熱|黃熱病 |
| 丙類傳染病(11種) | 肺結核 | 血吸蟲病 | 絲蟲病 | 包蟲病 | 麻風病 | 流行性感冒 | 流行性腮腺炎 | 風疹 | 新生兒破傷風 | 急性出血性結膜炎 | 除霍亂 | 痢疾 | 傷寒和副傷寒以外的感染性腹瀉病| 接吻病| 軍團病 |
消化系統疾病(三)
| 消化系統疾病一直是影響人類生存質量的主要疾病,特別是消化系統腫瘤更是嚴重威脅人類健康。醫學統計數據表明,屬於消化系統腫瘤的肝癌和胃癌長年來一直位於我國腫瘤發病率的第二位和第三位。 |
消化系統疾病
| 消化系統疾病一直是影響人類生存質量的主要疾病,特別是消化系統腫瘤更是嚴重威脅人類健康。醫學統計數據表明,屬於消化系統腫瘤的肝癌和胃癌長年來一直位於我國腫瘤發病率的第二位和第三位。 | |||
| 胃炎 急性胃炎 急性胃腸炎 胃潰瘍 慢性萎縮性胃炎 慢性胃炎 慢性淺表性胃炎 消化性潰瘍 胃腸道脹氣 腸上皮化生 胃癌 胃痛 急性胃擴張 胃柿石症 胃黏膜脫垂症 胃下垂 胃泌素瘤 傾倒綜合徵 胃扭轉 小腸腫瘤 阿狄森氏病 | 大腸癌 直腸癌 肛門直腸損傷 結腸直腸腺瘤 克隆氏病 腸中風 急性腸炎 慢性腸炎 急性腸梗阻 急性腸胃炎 偽膜性腸炎 放射性腸炎 直腸陰道瘺 腸結核 缺血性腸病 闌尾炎 急性闌尾炎 蛔蟲病 蟯蟲病 鉤蟲病 | 先天性肛門閉鎖 肛門瘺管 肛裂 肛門梳硬結 肛門濕疹 肛門直腸先天畸形 直腸脫垂 肛門瘙癢 大便失禁 肛管直腸癌 便秘 器質性便秘 功能性便秘 結腸性便秘 妊娠便秘 產褥期便秘 小兒便秘 急性細菌性痢疾 小兒便血 胃原性腹瀉 | 感染性腹瀉 食物中毒 腺病毒胃腸炎 慢性肝炎 小兒肝炎 藥物性肝炎 酒精性肝炎 肝昏迷 肝功能衰竭 肝細胞凋亡 肝腫大 黃疸 老年肝硬化 肝纖維化 門靜脈高壓症 肝腎綜合徵 肝吸蟲病 肝功能檢查 肝穿刺 肝移植術 |

